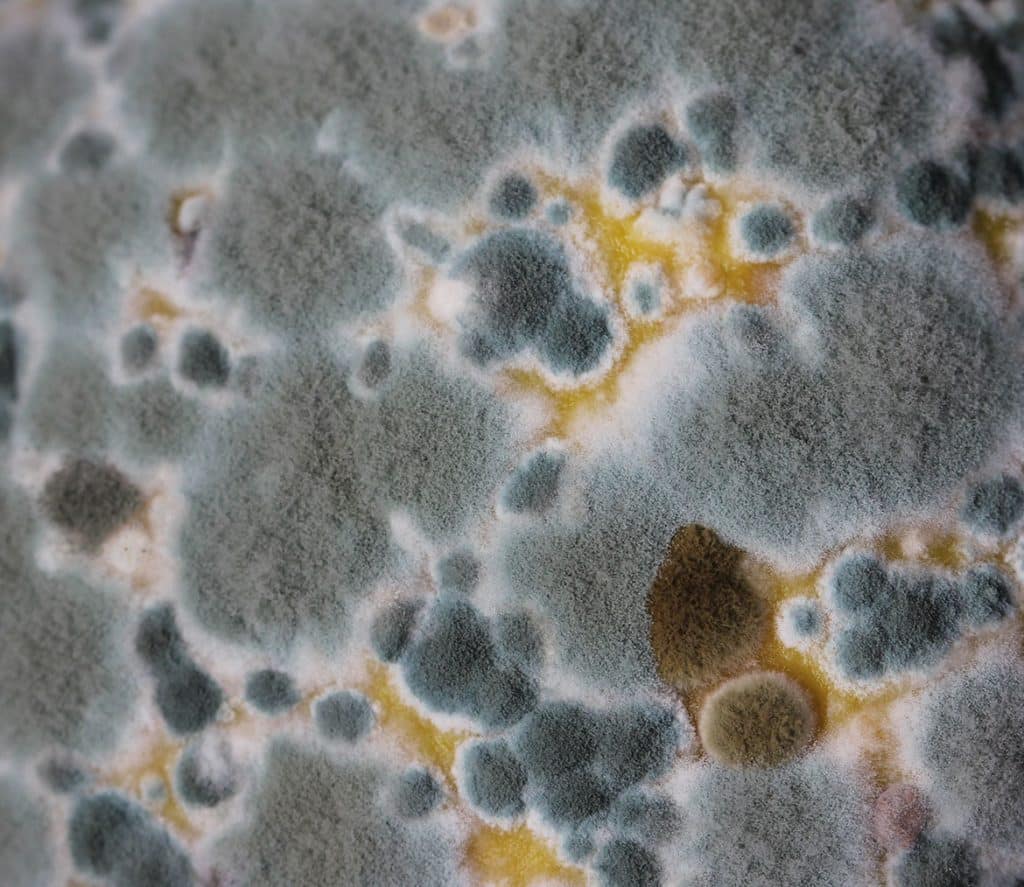
Identifying Moldy Foods

Every year, countless individuals fall victim to foodborne illnesses caused by a ubiquitous but often overlooked threat – mold. This common fungus, seemingly harmless at a glance, can pose significant health risks if ingested. From your kitchen counter to the confines of your refrigerator, mold silently thrives, tainting your food and jeopardizing your well-being. This guide offers comprehensive insights into understanding, identifying, and dealing with mold in your food.
Understanding What Mold Is Exactly
Mold represents a group of fungi found almost everywhere, even in the air we breathe. These microscopic organisms reproduce through spores, which can endure harsh conditions and lie dormant until conditions are conducive for growth. Mold manifests on food when these spores find a suitable host, often moist items and kept in warm environments.
Different types of mold exist, each with its characteristics and preferred host food. Some common types include Penicillium, often found on fruits and bread, and Aspergillus, commonly located in air conditioning systems and can contaminate food through the air. Recognizing these molds can be a vital first step in safeguarding one’s health.
The Health Risks Associated With Consuming Moldy Foods

Consuming moldy food carries a significant risk of foodborne illnesses, known as mycotoxicosis. Different molds produce varying mycotoxins, harmful compounds that can lead to adverse health effects. Depending on the type of mold and extent of exposure, symptoms can range from mild digestive discomfort to severe conditions like allergic reactions and respiratory distress.
More alarmingly, specific molds, like Aspergillus, produce aflatoxins, known carcinogens that can result in long-term health implications if frequently consumed. Other molds, such as Penicillium, can lead to digestive distress and allergic reactions. Identifying mold and avoiding consuming contaminated food becomes crucial in maintaining overall health.
Identifying Mold In Different Types Of Foods

While molds often present as fuzzy, discolored spots on the food surface, their appearance can vary based on the food type and mold species. Fruits and vegetables might exhibit white, blue, green, or black mold spots. Bread, particularly in humid conditions, can showcase greenish or bluish spots. Depending on its type, cheese can have mold ranging from white and green to blue and black.
However, mold isn’t always visually detectable. Changes in the smell or texture of food can also signal contamination. A sour or musty smell, or a slimy, velvety texture, could indicate the presence of mold. The existence of ‘invisible mold’ makes it imperative to exercise caution even when the food appears normal.
Think About The ‘When In Doubt, Throw it Out’ Rule

Exercising vigilance in food consumption is paramount when suspecting mold presence. If one encounters food with suspicious discoloration, unusual smell, or texture, it’s essential to err on the side of caution. Even if the mold is only visible in a small area, discarding the entire food item is safe, as the mold’s root system could have spread deeper.
Many might be tempted to cut off the moldy part and consume the rest, especially in seemingly firm foods like cheese or vegetables. However, this practice is risky. Mold spores can penetrate deep into the food, and removing the visible mold might not ensure the food’s safety.
Safe Food Storage To Prevent Mold

Proper food storage plays a pivotal role in inhibiting mold growth. Foods should be stored in clean, dry conditions, preferably in sealed containers. Maintaining a cool environment, typically through refrigeration, can slow mold growth, as most molds prefer warm conditions.
Controlling moisture is equally critical in food storage. High humidity or condensation can turn food storage into a thriving environment for mold. Therefore, it’s essential to keep stored food dry, avoid overpacking the refrigerator, and regularly check for signs of spoilage.
Myths and Misconceptions about Mold

Several myths about mold perpetuate, creating misconceptions about its safety. For instance, the notion that mold only exists on the food surface is misleading. As mold grows, its roots, or hyphae, penetrate the food’s depths, making superficial removal ineffective.
Another common myth suggests that some molds are safe to eat. While certain cheese varieties employ specific mold types for flavoring, these are carefully cultivated under controlled conditions. In contrast, mold appearing on everyday food is unpredictable, potentially carrying harmful toxins.
Steps To Take If You’ve Consumed Moldy Food

If someone inadvertently consumes moldy food, the initial response should be to monitor for any adverse reactions. Depending on the mold type and individual health status, symptoms can manifest as nausea, vomiting, diarrhea, or allergic reactions. Drinking plenty of fluids can help reduce mild symptoms.
However, medical attention should be sought promptly if symptoms persist or worsen. Inform the healthcare provider about mold ingestion to ensure appropriate treatment. Given their potential long-term health effects, regular check-ups might be necessary for cases involving mold exposure producing aflatoxins.
Actions To Take if Mold Is A Frequent Problem

If mold appears frequently in your home or kitchen, it might indicate a deeper problem than improper food storage. Persistent mold presence could point to higher-than-normal moisture levels or sub-optimal ventilation in the kitchen or pantry, creating a conducive environment for mold growth. A thorough assessment of your kitchen and storage spaces may be necessary, checking for possible leakages or damp areas and ensuring proper ventilation.
Moreover, seek professional help if the problem persists despite your best efforts. Certain mold strains can be tenacious and potentially harmful, making professional remediation a safer choice. It’s also important to remember that mold spores can float in the air and settle on surfaces, so regular cleaning and dry food storage can go a long way toward maintaining a mold-free environment.
The Bottom Line
In the world of food safety, vigilance is key. From understanding what mold is, and recognizing its presence in our food, to understanding the myths and realities of mold consumption, this knowledge is a step towards ensuring our well-being. In the fight against foodborne illnesses, remember the golden rule – when in doubt, throw it out. Share this guide to help others recognize and respond to this quiet menace lurking in our kitchens.